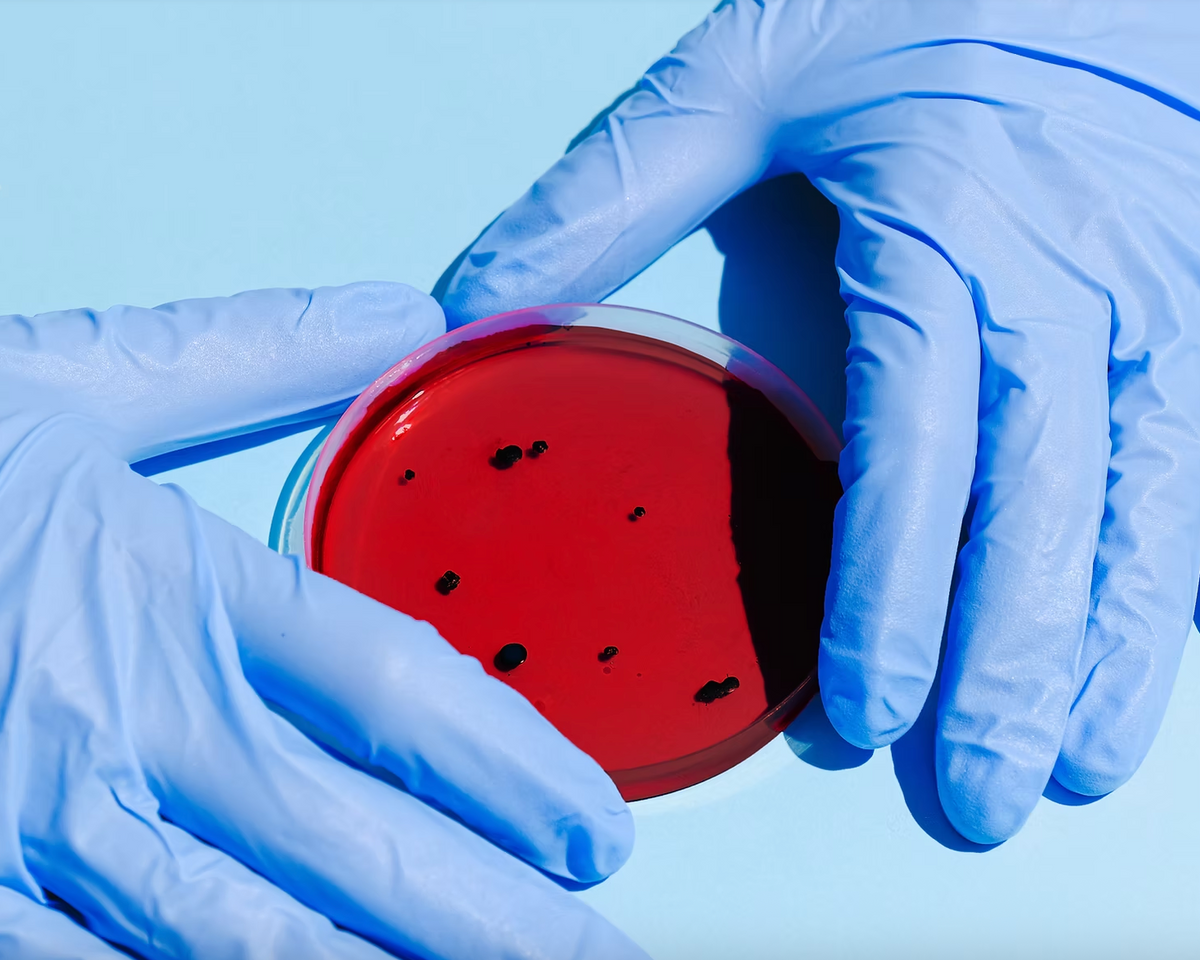
Does Hypochlorous Acid Kill Good Bacteria?

Hypochlorous acid (HOCl) has become a skincare favorite for its ability to fight off bacteria, viruses, and fungi—all while being gentle on your skin. But here’s a real concern: does it also harm the good bacteria that keep your skin healthy? Let’s unpack what HOCl does and how it works with your skin.
What Is Hypochlorous Acid?
Think of hypochlorous acid as your body’s natural disinfectant. Your immune system actually makes HOCl to fight infections and heal wounds. In skincare, it’s loved for a few key reasons:
-
It clears acne-causing bacteria.
-
It soothes redness and irritation.
-
It helps cuts and blemishes heal faster.
It’s gentle enough for daily use but strong enough to get the job done. Still, you might wonder—what about the friendly bacteria your skin relies on?
How Does Hypochlorous Acid Work?
HOCl works by breaking down the outer walls of harmful bacteria, viruses, and fungi. It’s like a tiny clean-up crew for your skin, targeting the bad stuff while leaving your skin feeling fresh. But does it sometimes hit the good bacteria too? Let’s break it down.
Does HOCl Affect Good Bacteria?
Here’s the honest truth: yes, it can, but it’s not something to lose sleep over. Here’s why:
-
It Focuses on the Bad Stuff: HOCl is really good at targeting harmful bacteria. While it might affect some good bacteria, it’s not going to wipe out your skin’s entire microbiome.
-
It’s Short-Lived: Once HOCl finishes its job, it breaks down into saltwater. That means it doesn’t linger long enough to cause serious disruption.
-
Skincare Formulas Are Balanced: Most HOCl products are designed to work with your skin, not against it. They strike a balance between fighting bad bacteria and preserving the good stuff.
So, when used correctly, HOCl won’t throw your skin out of balance.
How to Use HOCl Without Worrying About Your Skin’s Microbiome
Want to make the most of HOCl while keeping your skin’s good bacteria happy? Here’s how:
-
Follow the Directions: Stick to the instructions on the label. A little goes a long way.
-
Keep Your Skin Hydrated: A good moisturizer helps maintain your skin’s natural defenses.
-
Don’t Overdo It: You don’t need to drench your skin in HOCl. Just a few sprays or dabs are enough.
-
Replenish with Probiotics: If you’re worried about your microbiome, skincare products with probiotics can help replenish the good bacteria.
-
Try: Mother Dirt AO+ Mist
-
Why HOCl Beats Harsh Antiseptics
Here’s the deal: HOCl is so much kinder to your skin than alcohol-based sanitizers or hydrogen peroxide. Those harsh options strip your skin of both good and bad bacteria, often leaving it dry and irritated. HOCl is non-toxic, non-drying, and gentle on your skin’s natural balance. It’s a no-brainer.
FAQs
1. Will HOCl Kill All My Skin’s Good Bacteria?
Not at all! HOCl is selective. When used properly, it targets harmful bacteria while leaving most of your good bacteria intact.
2. How Do I Know If My Skin’s Microbiome Is Out of Whack?
Dryness, redness, or extra sensitivity can all be signs. If this happens, try cutting back on HOCl and adding microbiome-friendly products to your routine.
Final Thoughts
Hypochlorous acid is a skincare game-changer. It’s powerful against harmful bacteria but gentle enough to keep your skin happy and healthy. Just remember to pair it with a great moisturizer and probiotic-friendly products to support your skin’s balance.
Want to give it a try? Check out our Hypochlorous Acid Spray on Amazon USA or Amazon Canada

Want to dig deeper into HOCl? Check out our latest blog: Should I Moisturize After Applying Hypochlorous Acid?
Disclaimer: This article is for informational purposes only and isn’t a substitute for professional advice. Always consult a dermatologist before trying new skincare products, and don’t forget to patch test!
Reference:
Johnson, T., Moore, L., & Clark, P. (2020). Antimicrobial Effects of Hypochlorous Acid on Human Skin Microbiota. Journal of Dermatological Science, 89(2), 152-160. DOI: 10.1016/j.jdermsci.2020.01.002
Written by
Honeydew Labs Team
















